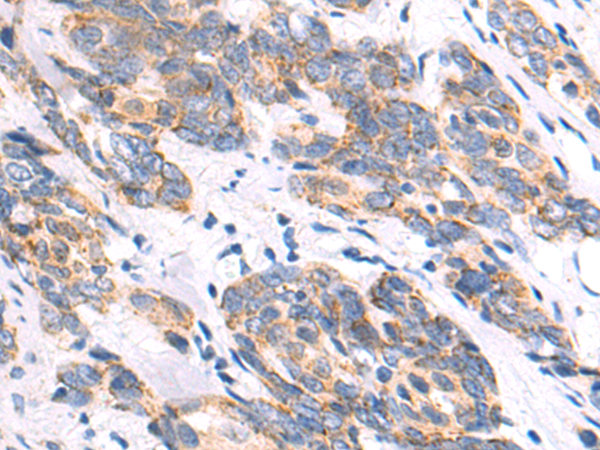
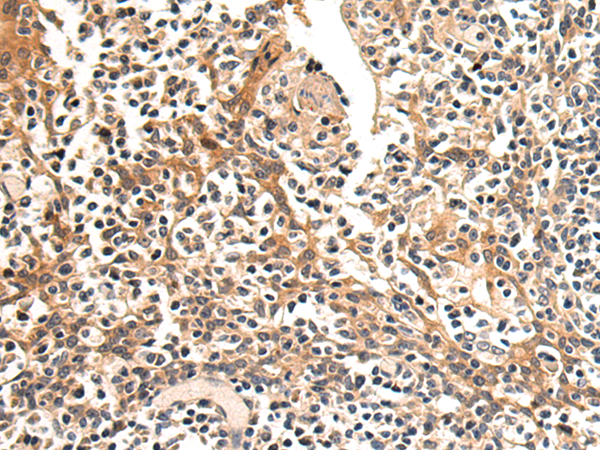
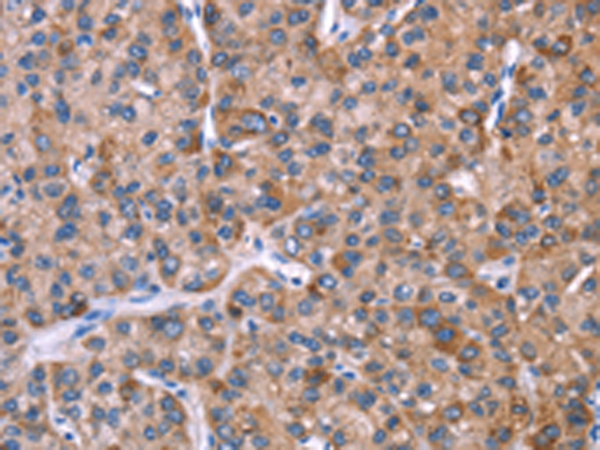

-
分类: 科研抗体货号: P04879别名: ATOD2应用: IHC反应种属: Human
-
分类: 科研抗体货号: P04874别名: F1AA; F1A-ALPHA; FEM1-beta应用: WB,IHC反应种属: Human, Mouse, Rat
-
分类: 科研抗体货号: P04914别名: H963应用: WB,IHC反应种属: Human
-
分类: 科研抗体货号: P04873别名: C4orf7; FDC-SP应用: IHC反应种属: Human
-
分类: 科研抗体货号: P04889别名: GAT1; GABATR; GABATHG应用: WB,IHC反应种属: Human, Mouse, Rat
-
分类: 科研抗体货号: P04907别名: NP60; BM045; HIBDL; N-PAC应用: IHC反应种属: Human, Mouse, Rat
-
分类: 科研抗体货号: P04867别名: FAIM1应用: WB,IHC反应种属: Human, Mouse, Rat
-
分类: 科研抗体货号: P04888别名: FXR1P; MYOPMIL; MYORIBF应用: WB,IHC反应种属: Human, Mouse, Rat
-
分类: 科研抗体货号: P04904别名: GGR; GL-R应用: WB,IHC反应种属: Human, Mouse, Rat
-
分类: 科研抗体货号: P04861别名: LBN应用: IHC反应种属: Human

鄂公网安备42018502007531号
鄂公网安备42018502007531号

